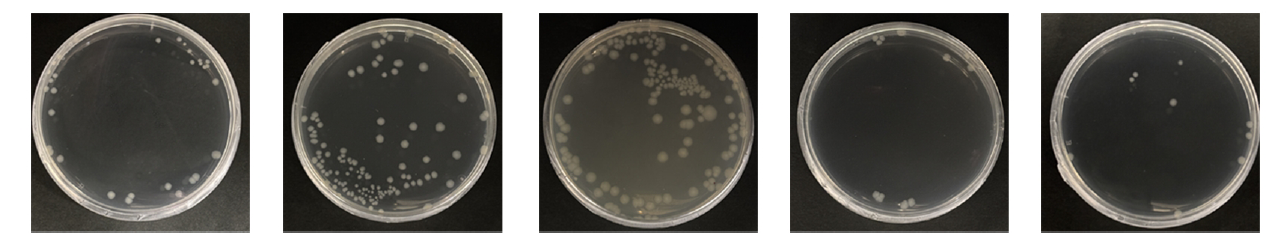
table1.png
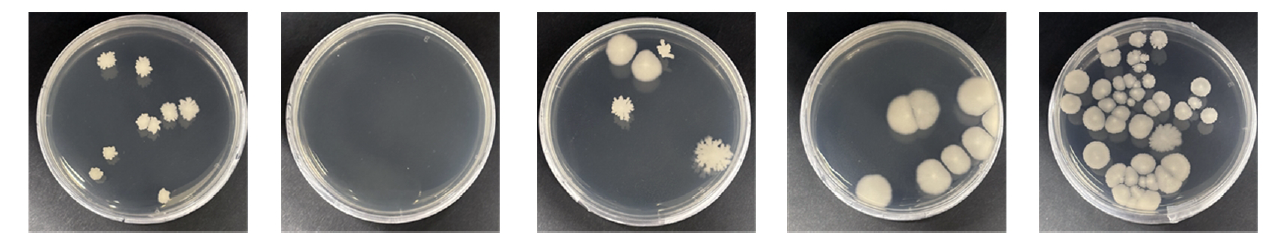
table2.png

이유진 , 이정순
회화나무 추출물을 함유한 PVA 나노섬유의 제조 및 특성
Preparation and Characterization of Sophora Japonica L Extracts Loaded Polyvinyl Alcohol Nanofibers
Yujin Lee, Jungsoon Lee
Abstract: Electrospun nanofibers are promising materials for biomedical and cosmetic applications owing to their high porosity, large surface area, and effective moisture control. In this study, polyvinyl alcohol (PVA) nanofibers loaded with Sophora Japonica L. extracts were fabricated by electrospinning, and their structural, antioxidant, and antibacterial properties were evaluated. Extracts from Sophorae flos and Sophorae fructus were prepared using water and 60% ethanol, and their antioxidant activities were assessed by total polyphenol and flavonoid contents as well as DPPH and ABTS radical scavenging assays. The antioxidant activity varied depending on the plant part and extraction solvent, with Sophorae flos ethanol extracts showing the highest activity. PVA nanofibers containing different extract concentrations were successfully fabricated, and uniform fiber morphology was obtained at optimal loading levels. FT-IR and DSC analyses revealed physical interactions and hydrogen bonding between PVA and the extracts, accompanied by reduced crystallinity at higher extract contents. The antioxidant activity of the extracts was retained after incorporation into the nanofibers, with ABTS radical scavenging activity approaching complete scavenging over time. In addition, the extract-loaded PVA nanofibers exhibited antibacterial activity against Escherichia coli and Staphylococcus aureus. These results suggest that Sophora Japonica L. extract-loaded PVA nanofibers have strong potential as biofunctional materials for wound dressings and skincare applications.
Keywords: Sophora Japonica L. extract , polyvinyl alcohol(PVA) , electrospinning , nanofiber , antioxidant activity , antibacterial activity
1. 서 론
다양한 고분자와 첨가제를 쉽게 적용할 수 있는 전기방사 나노섬유는 첨단 소재 개발의 핵심 분야이다. 특히, 전기방사 나노섬유의 초미세 기공(ultra-fine pores) 구조는 우수한 통기성, 수분 및 체액 조절, 외부 물질 침입 억제 등의 특징이 있으며[1] 다양한 기능성 약물을 적재하여 피부 재생 및 치유 효과가 있어[2] 마스크 시트나 상처 드레싱, 기능성 패치 등으로 활용 가능하다[3−5]. 나노섬유의 높은 다공성과 가변성, 비표면적이 큰 구조적 특징으로 인해 기성 제품보다 피부 밀착력이 매우 뛰어나며[6] 약물 전달 및 확산에 유리할 뿐만 아니라 섬유 자체에 기능성 물질을 첨가하여 지속적인 약물 방출이 가능하다[7].
회화나무(Sophora Japonica L.)는 콩목 콩과에 속하는 여러해살이풀로, 회나무, 괴나무로도 불리며 꽃과 열매, 뿌리 모두 약용할 수 있다[8]. 회화나무 꽃(괴화, Sophorae flos)과 열매(괴각, Sophorae fructus)에는 플라보노이드(flavonoids) 및 이소플라보노이드(isoflavonoids) 화합물이 다량 함유되어 체외 및 채내 생물 활성 및 지혈 작용, 항산화, 항염증, 항균 및 항바이러스 등의 효과가 보고된다[9]. 한방에서는 괴화가 염증을 가라앉히고 항출혈 작용을 하며 괴각에는 화상 및 골절 회복, 산후조리 등의 효능이 있어 목적에 따라 달리 사용되는 것으로 알려져 있다[10]. 괴화는 다량의 rutin을 비롯한 quercetin, vitamin C, vitamin E, β-carotene, Mn, Zn, Cu 등을 함유하고 있으며[11] 괴각은 rutin과 quercetin 같은 플라보노이드 외에도 genistin, sophoricoside, kaempferol 등 이소플라보노이드를 포함한 다양한 유효 성분이 함유되어 있다[12]. 괴화와 괴각은 총 폴리페놀 및 플라보노이드 함량, 라디칼 소거능 평가를 통해 높은 항산화 효과가 검증되어 회화나무 추출물의 천연 항산화제 가능성, 피부 및 탈모 개선 효과가 입증되어[13−15] 기능성 천연 물질로서의 다양하게 활용될 수 있을 것으로 기대된다.
PVA(polyvinyl alcohol)는 친수성이 높아 물에 쉽게 용해되며 독성이 없고 생체적합성이 우수하여[16] 천연추출물의 장점을 뒷받침할 기반 고분자로 적절하다. 선행연구에서도 clindamycin 및 propolis[17], 우단담배풀(V. Thapsus) 추출물[18], chitosan[3] 등 천연 유래 물질을 적재한 PVA 나노섬유 제조 연구가 다수 이루어지고 있다. 특히, 합성 고분자는 기계적 강도가 비교적 높은 반면, 천연 고분자에 비해 세포와의 상호작용이 적게 나타나는 단점이 있으나, PVA는 이러한 기계적 특성 및 세포 부착 수준을 보완할 수 있으며[18] 위험 수준의 노출량을 의미하는 [TeX:] $$\mathrm{LD}_{50}$$값이 매우 높아 급성 독성 및 장기적인 피부 노출에도 안정적이며 눈가 자극, 알레르기 유발, 피부 자극성 등에서 임상적으로 유의미한 문제가 일어나지 않아 코스메틱 분야에서 사용하기 안전하다는 평가가 보고되었다[19]. 따라서 첨가 물질의 기능성에 따라 다양한 용도의 PVA 나노섬유를 제조할 수 있으며 회화나무 추출물을 함유한 PVA 나노섬유를 제조하여 의료 및 피부 미용 분야에서 활발하게 사용될 수 있을 것으로 예상되나, 현재 관련 연구가 미비한 상황이다.
따라서 본 연구는 회화나무 추출물의 부위와 용매에 따른 항산화 효과를 평가하고 전기방사를 통해 회화나무 추출물을 첨가한 PVA 나노섬유를 제조하였다. 제조된 나노 섬유는 회화나무 추출물의 첨가 농도에 따라 제조 형태 및 구조적 특징, 열적 거동의 변화를 평가하였으며 부위 및 용매별로 전기방사성이 우수한 농도의 나노섬유를 선정하여 항산화 및 항균 활성을 측정하여 회화나무 추출물을 함유한 PVA 나노섬유의 활용 가능성을 모색하고자 하였다.
2. 실 험
2.1. 시료 및 시약
본 실험에 사용된 회화나무는 한솔제약과 ㈜풍산에서 제 조된 건조 괴화와 괴각을 그라인더에 분쇄한 것으로, 방사 용액의 고분자는 폴리비닐알콜(Singma Aldrich Co., USA) 을 사용하였다. 폴리페놀과 플라보노이드 함량 측정을 위 한 표준물질로 각각 갈릭산(Gallic acid, >98%, Tokyo Chemical Industry, Japan)과 퀘르세틴(Quercetin, >95%, Sigma Aldrich Co., USA)을 사용하였으며, 폴린-시오칼토 시약(Folin-ciocalteu’s phenol reagent, 2M, Sigma Aldrich Co., USA), 아세트산 칼륨(Potassium acetate, >99%, Sigma Aldrich Co., USA), 질산 알루미늄(Aluminum nitrate nonahydrate, >98%, Sigma Aldrich Co., USA), 탄산 나트륨 (Sodium carbonate, 99.0%, Samchun, Korea) 등이 사용되었 다. 라디칼 소거 활성에는 2,2-diphenyl-1-picrylhydrazyl (DPPH, ≥95%), 2,2'-azino-bis (3-ethylben zothiazoline 6- sulfonic acid) diammonium salt (ABTS, ≥98.0%), 과황산칼 륨(Potassum persulfate, 99.0%, Samchun, Korea) 등이 사용 되었다. 항균성 평가를 위해 신슈대학교 Dr. Ogasawara의 연구실에서 제공받은 대장균(E. coli) 및 황색포도상구균(S. aureus)을 사용하였으며, Nutrient agar(NA, No. 70148- 100G, Sigma Aldrich Co., USA), Nutrient broth(No. 70122- 100G, Sigma Aldrich Co., USA)로 제작한 NA배지에서 배 양하였다.
2.2. 회화나무 추출물 제조
괴각과 괴화는 그라인더(grinder)에 60초 이상 분쇄한 분말을 사용하였다. PVA는 수용성이 높아 물에 혼합하거나 용해하는 것이 가장 유리하며[16] 플라보노이드류는 중간 극성에서 추출 효율이 가장 높으므로[20,21] 전기방사성 및 기능성 효율을 비교하기 위해 3등급의 물(이하 물)과 60% 에탄올을 용매로 추출하였다. 온도는 물 [TeX:] $$100^{\circ} \mathrm{C},$$ 60% 에탄올 [TeX:] $$60^{\circ} \mathrm{C}$$로 용매에 따라 다르게 하였으며 액비 1:20으로 60분간 침지하여 얻은 추출물을 진공여과장치(Filtering Apparatus, Korea Ace Scientific Inc., Korea)로 여과하는 과정을 3회 반복하였다. 추출물은 회전증발농축기(RV10, IKA®, Germany)를 이용하여 [TeX:] $$100^{\circ} \mathrm{C}$$에서 90 rpm으로 감압농축하였다. 수율은 추출에 사용된 회화나무 꽃과 열매의 무게에 대한 추출물의 고형분 함량을 백분율로 계산하였으며, 각각의 수율은 Table 1과 같이 나타났다. 최종 추출물을 얻기 위해 동일한 용매로 녹인 50% stock solution을 실험에 사용하였다.
Table 1.
| Material | Solvent | Yield (%) |
|---|---|---|
| Sophorae Fructus | Water | 52.65 |
| 60% Ethanol | 49.45 | |
| Sophorae Flos | Water | 31.40 |
| 60% Ethanol | 41.25 |
2.3. 회화나무 추출물의 총 폴리페놀 및 플라보노이드 함량
회화나무 추출물의 항산화 평가를 위해 총 폴리페놀 및 플라보노이드 함량을 측정하였다.
총 폴리페놀 함량 측정을 위해 추출물 0.4 ml와 폴린-시오칼토 시약 1 ml를 암실에서 5분간 반응시킨 뒤, 7.5% 탄산나트륨 2 ml를 추가해 암실에서 1시간 동안 반응시켰다. 반응한 용액은 자외·가시광선 분광광도계(UV-vis Spectrophotometer, S-3100, Shinco, Korea)를 사용하여 765 nm에서 흡광도를 측정하였다[22]. 총 폴리페놀 함량은 갈릭산을 31.25, 62.5, 125, 250 μg/ml 농도에서 측정한 표준 검량선을 기준으로 측정하였다.
총 플라보노이드 함량 측정을 위해 추출물 0.5 ml와 99.9% 에탄올 1.5 ml, 10% 질산 알루미늄 0.1 ml, 1M 아세트산 칼륨 0.1 ml, 물 2.8 ml를 혼합하여 암실에서 30분간 반응시켰다. 반응한 용액은 자외·가시광선 분광광도계를 사용하여 415 nm에서 흡광도를 측정하였다[23]. 총 플라보노이드 함량은 퀘르세틴을 62.5, 125, 250, 500 μg/ml 농도에서 측정한 표준검량선을 기준으로 측정하였다.
2.4. 회화나무 추출물의 DPPH 및 ABTS 라디칼 소거 활성
회화나무 추출물의 항산화 평가를 위해 DPPH 및 ABTS 라디칼 소거능을 측정하였다.
DPPH 라디칼 소거능을 측정하기 위해 1, 2, 3, 4 mg/ml 농도로 희석한 추출물 0.1 ml와 0.4 mM DPPH 용액 1 ml, 99.9% 에탄올 1.4 ml를 혼합하여 암실에서 30분간 반응시켰다. 반응한 용액은 자외·가시광선 분광광도계를 사용하여 517 nm에서 흡광도를 측정하였다[24].
ABTS 라디칼 소거능을 측정하기 위해 14 mM ABTS 용액과 4.9 mM 과황산칼륨을 1:1로 혼합하여 12−16시간 동안 암실에서 반응시킨 뒤 734 nm에서 흡광도가 0.7−0.8이 되도록 물로 희석하였다. 희석된 0.95 ml의 [TeX:] $$ABTS^+$$ 용액과 1, 2, 3, 4 mg/ml 농도로 희석된 추출물 0.05 ml를 혼합하여 10분간 암실에서 반응시킨 뒤 734 nm에서 흡광도를 측정하였다[25].
최종 DPPH 및 ABTS 라디칼 소거능은 식 (1)을 사용하여 계산되었다.
[TeX:] $$A_s$$: absorbance of sample
[TeX:] $$A_c$$: absorbance of control
2.5. 회화나무/PVA 나노섬유 제조
회화나무 추출물을 함유한 PVA 나노섬유를 제조하기 위해 예비실험을 거쳐 전기방사성이 가장 우수한 농도와 방사조건을 선정하였다. PVA 고분자를 물에 녹여 11 wt% 용액을 제조한 뒤 회화나무 추출물을 5, 10, 20 wt%로 첨가하여 12시간 이상 교반하고 1시간 동안 초음파 처리하였다. 방사용액의 점도는 점도계(Viscometer, DV1 prime, Brookfield, USA)를 이용해 S62 스핀들(spindle), 20 rpm 조건으로 실온[TeX:] $$\left(20 \pm 2^{\circ} \mathrm{C}, 24 \pm 5 \% \mathrm{RH}\right)$$ 환경에서 10회 반복 측정하였다. 전기방사는 전압 15 kV, 방사거리 15 cm, 유속 2ml/h 조건에서 실시하였으며 제조된 회화나무/PVA 나노 섬유는 실온에서 보관되었다.
2.6. 회화나무/PVA 나노섬유의 구조 및 물성 분석
회화나무/PVA 나노섬유의 형태를 관찰하기 위해 주사전자현미경(Scanning electron microscopy, JSM-6010LA, JEOL Ltd., Tokyo, Japan)을 이용하여 나노섬유 표면 이미지를 얻었으며 이미지 분석 프로그램(Image Processing and Analysis, ImageJ, NIH, USA)을 통해 100개의 섬유를 임의로 선정하여 섬유 직경의 평균을 구하였다.
회화나무/PVA 나노섬유의 구조적 특성을 확인하기 위해 표면반사 적외선 분광기(FT-IR spectrophotometer, Alpha-P, Bruker, Germany)를 이용하여 적외선흡수스펙트럼을 분석하였다.
회화나무/PVA 나노섬유의 열적 거동을 확인하기 위해 시차주사열량계(Differential Scanning Calorimeter, DSC 204 F1 Phoenix, Netzsch, Germany)를 이용하였으며, 질소 분위기 하에 승온속도 [TeX:] $$10^{\circ} \mathrm{C} / \mathrm{min},$$ 온도 [TeX:] $$25-250^{\circ} \mathrm{C}$$ 사이의 열용량 변화를 측정하였다.
2.7. 회화나무/PVA 나노섬유의 ABTS 라디칼 소거 활성
회화나무 추출물과 비교하여 회화나무/PVA 나노섬유의 항산화 효과의 변화를 확인하기 위해 ABTS 라디칼 소거능을 측정하였다. 7 mM ABTS 용액과 2.45 mM 과황산칼륨을 1:1로 혼합하여 12−16시간 동안 암실에서 반응시킨 뒤 734 nm에서 흡광도가 1.0±0.01이 되도록 80% 에탄올을 사용하여 희석하였다. 희석된 3 ml [TeX:] $$ABTS^+$$ 용액에 나노섬유 1 mg을 넣고 암실 반응시켰으며 5, 15, 30, 45, 60, 90, 150 분마다 흡광도를 측정하여 최종 라디칼 소거능을 식 (1)에 따라 계산하였다.
2.8. 회화나무/PVA 나노섬유의 항균성
회화나무/PVA 나노섬유의 항균성을 확인하기 위해 평판 계수법(plate count method, KS K ISO 20743)을 참고하여 대장균과 황색포도상구균에 대한 항균성을 측정하였다. 각 균을 24시간 배양하여 튜브에 1 ml씩 옮겨 3000 rpm으로 2000초 동안 2회 원심분리하여 워싱하였다. 워싱한 균의 Optical density(OD)를 1.0으로 조정하고 멸균된 나노섬유(5×5 cm)에 200 μl를 접종하여 [TeX:] $$28^{\circ} \mathrm{C}$$ 인큐베이터에서 24시간 배양하였다. 24시간 후 나노섬유를 멸균수가 담긴 falcon tube에 넣어 vortexing 및 초음파 처리를 각 30초씩 3회 반복하여 나노섬유에 배양된 세균을 탈착시켰다. 해당 용액을 NA 배지에 100 μl 도말하여 실링한 뒤 [TeX:] $$28^{\circ} \mathrm{C}$$ 인큐베이터에서 24시간 동안 배양하였다. 배양된 균의 콜로니 수는 식 (2)에 따라 CFU(colony forming units) 산출법으로 계산되었다.
N: number of colonies
D: dilution factor
V: volume plated (ml)
3. 결과 및 고찰
3.1. 회화나무 추출물의 총 폴리페놀 및 플라보노이드 함량
회화나무 추출물의 총 폴리페놀 및 플라보노이드 함량은 Figure 1과 같다. 총 폴리페놀 함량은 괴화 60% 에탄올 추출물이 625(±2.26) mg GAE/g로 가장 높게 나타났으며, 괴각 물 추출물이 366(±1.34) mg GAE/g으로 가장 낮게 나타났다. 총 플라보노이드 함량 또한 괴화 60% 에탄올 추출물이 1450(±3.14) mg QE/g으로 가장 높게 나타났으며, 괴각 물 추출물이 338(±1.72) mg QE/g로 가장 낮게 나타났다. 이를 통해 괴각보다 괴화, 물보다 60% 에탄올 추출물의 총 폴리페놀 및 플라보노이드 함량이 높음을 알 수 있으며 용매에 따른 차이는 중간 수준의 극성을 지닌 에탄올의 플라보놀 배당체(flavonol glycosides)의 추출 효율이 높기 때문임을 알 수 있다[26].
3.2. 회화나무 추출물의 DPPH 및 ABTS 라디칼 소거 활성
회화나무 추출물의 DPPH 및 ABTS 라디칼 소거능은 Figure 2와 같다. 4 mg/ml 농도에서 비교할 때, DPPH 라디칼 소거능은 괴화 60% 에탄올 추출물이 79.91%로 가장 높게 나타났으며 괴각 물 추출물이 31.70%로 가장 낮게 나타났다. ABTS 라디칼 소거능 또한 괴화 60% 에탄올 추출물이 97.80%로 가장 높고 괴각 물 추출물이 52.56%로 가장 낮게 나타났다. 전반적인 농도에서 괴각보다 괴화, 물보다 60% 에탄올 추출물의 라디칼 소거능이 더 높게 나타났으며 이는 총 폴리페놀 및 플라보노이드 함량과 경향이 일치하였다.
Figure 1.

Figure 2.

3.3. 회화나무/PVA 방사용액의 점도 및 나노섬유의 형태
회화나무 추출물을 함유한 PVA 나노섬유 제조를 위해 괴각 물 추출물과 60% 에탄올 추출물, 괴화 물 추출물과 60% 에탄올 추출물을 각각 0, 5, 10, 20 wt%로 첨가하여 방사용액을 제조하였다. 제조된 회화나무 추출물 함유 PVA 고분자 용액의 점도 측정 결과는 Table 2에 나타냈다. 추출물을 첨가하면 추출물을 첨가하지 않았을 때에 비해 용액의 점도가 증가하나, 추출물 첨가 농도가 증가할수록 점도가 소폭 감소하는 경향이 나타났다. 추출물을 첨가하였을때 점도가 증가하는 현상은 대부분의 선행연구에서 관찰할 수 있으나[27,28], 첨가제가 고분자와 상호작용할 수 있는 농도 수준을 넘어서면 점도가 다시 감소하는 비선형적 변화가 일어난 것으로 추측된다[29].
Table 2.
| Material | Solvent | Concentration (wt%) | Viscosity (cP) |
|---|---|---|---|
| Sophorae fructus | Water | 0 | 764 ± 1.05 |
| 5 | 1314 ± 2.16 | ||
| 10 | 1301 ± 1.42 | ||
| 20 | 1156 ± 9.13 | ||
| 60% Ethanol | 0 | 764 ± 1.05 | |
| 5 | 1490 ± 2.33 | ||
| 10 | 1283 ± 4.66 | ||
| 20 | 942 ± 0.63 | ||
| Sophorae flos | Water | 0 | 764 ± 1.05 |
| 5 | 1521 ± 2.98 | ||
| 10 | 1521 ± 2.21 | ||
| 20 | 1212 ± 1.15 | ||
| 60% Ethanol | 0 | 764 ± 1.05 | |
| 5 | 1228 ± 4.35 | ||
| 10 | 1127 ± 1.03 | ||
| 20 | 1110 ± 0.63 |
제조된 회화나무/PVA 나노섬유의 형태는 Figure 3에 나노섬유의 직경 평균과 표준편차는 Figure 4에 나타내었다. 대부분 추출물의 함량이 증가할수록 평균 직경과 표준편차가 증가하였으며 괴각 물 추출물을 함유한 나노섬유는 361−435 nm, 괴각 60% 에탄올 추출물을 함유한 나노섬유는 372−438 nm, 괴화 물 추출물을 함유한 나노섬유는 377−484 nm, 괴화 60% 에탄올 추출물을 함유한 나노섬유는 389−525 nm 범위의 직경을 나타냈다. 회화나무 추출물 함량이 5−10 wt% 수준일 때는 작고 균일한 직경을 보인 반면, 20 wt%로 고농도 첨가한 경우는 괴각 물 추출물을 제외하고 상대적으로 크고 불균일한 직경의 섬유가 다수 형성되었다. 이는 추출물의 농도나 방사용액의 점도가 너무 낮거나 높으면 비드(bead)가 발생하고 섬유를 형성하기 어렵기 때문이며[30] 추출물 함량이 높을수록 직경이 증가하고 불균일해지며 일부 비드가 형성되는 현상은 많은 선행 연구의 경향과 일치한다[27−31].
Figure 3.

Figure 4.

3.4. 회화나무/PVA 나노섬유의 적외선 흡수 스펙트럼
제조된 회화나무/PVA 나노섬유의 적외선 흡수 스펙트럼을 비교한 결과를 Figure 5에 나타내었다. 괴화/PVA 나노 섬유의 FT-IR 스펙트럼은 3328 cm-1에서의 O–H 신축 진동, 2924–2938 cm-1에서의 CH2 신축 진동, 1735 cm-1에서의 잔류 카르보닐 신축 진동, 그리고 1091 cm-1 및 1027 cm-1에서의 C–O 신축 진동을 포함하여 PVA의 특징적인 흡수 밴드를 보여주었다[32]. 이는 추출물을 첨가한 후 새로운 흡수 피크는 관찰되지 않았으며, 이는 전기방사 과정에서 새로운 공유 결합이 형성되지 않았음을 나타낸다. 3328 cm-1 및 1091 cm-1 피크 강도는 추출물의 종류와 함량에 따라 초기에는 변화를 보였지만, 절대적인 피크 강도에만 의존한 해석은 기준선 변동 및 신호(signal) 대 잡음(noise) 비의 영향을 받을 수 있다. 1091 cm-1 부근의 PVA 결정화 민감 밴드와 1027 cm-1 부근의 비정질 관련 밴드는 PVA 시스템의 결정화도 변화를 평가하는 데 널리 사용되어 왔으며, 특히 절대 강도 비교보다는 상대적인 밴드 비율 분석을 통해 평가하는 데 유용하다[33]. 따라서 강도 차이에 대한 과도한 해석을 피하기 위해 스펙트럼을 정규화하여 비교했다. 정규화된 조건에서 전체적인 밴드 위치는 모든 시료에서 거의 변화가 없었으며, 이는 PVA의 기본적인 화학 구조가 보존되었음을 나타낸다. 밴드 모양과 강도 분포에서 미묘한 차이가 관찰되었는데, 이는 PVA의 하이드록실기와 추출물의 페놀 성분 사이의 수소 결합과 같은 분자간 상호작용을 반영하는 것일 수 있다. 그러나 이러한 상호작용은 화학적이라기보다는 물리적인 것으로 보인다. 종합적으로, FT-IR 분석 결과는 괴화 추출물 첨가가 PVA의 기본 고분자 골격을 변화시키지는 않았지만, 구조적 변형없이 약한 분자간 상호작용을 유도했을 가능성을 시사한다.
Figure 5.

3.5. 회화나무/PVA 나노섬유의 열적 특성
제조된 회화나무/PVA 나노섬유의 열적 거동을 확인한 결과는 Figure 6에 나타내었다. 괴각 물 추출물을 함유한 나노섬유의 유리전이온도[TeX:] $$\left(\mathrm{T}_{\mathrm{g}}\right)$$는 농도 증가에 따라 [TeX:] $$74.3^{\circ} \mathrm{C}$$에서 [TeX:] $$103.4^{\circ} \mathrm{C}$$로 증가하였으며, 괴각 60% 에탄올 추출물을 함유한 나노섬유의 [TeX:] $$\mathrm{T}_{\mathrm{g}}$$는 [TeX:] $$87.6^{\circ} \mathrm{C}$$에서 [TeX:] $$93.2^{\circ} \mathrm{C}$$로 증가하는 경향을 보였다. 반면, 괴화 물 추출물을 함유한 나노섬유의 [TeX:] $$\mathrm{T}_{\mathrm{g}}$$는 [TeX:] $$90.5^{\circ} \mathrm{C}$$에서 [TeX:] $$83.9^{\circ} \mathrm{C}$$로 감소하였으며, 괴화 60% 에탄올 추출물을 함유한 나노섬유의 [TeX:] $$\mathrm{T}_{\mathrm{g}}$$는 [TeX:] $$92.2^{\circ} \mathrm{C}$$에서 [TeX:] $$91.2^{\circ} \mathrm{C}$$로 추출물 첨가로 인해 [TeX:] $$\mathrm{T}_{\mathrm{g}}$$가 상승한 후로 변화가 없거나 소폭 감소하는 경향이 나타났다. 이는 사슬이 경직화되면서 PVA 고분자가 추출물과 물리적인 결합을 이루었기 때문으로 추측되며, 추출물이 적정 수준을 초과하면 PVA 사슬 간 자유 부피를 증가시켜 분자의 운동성을 높여 [TeX:] $$\mathrm{T}_{\mathrm{g}}$$가 감소한 것으로 추측된다[34].
Figure 6.

융점[TeX:] $$\left(\mathrm{T}_{\mathrm{m}}\right)$$의 경우, 괴각 물 추출물을 함유한 나노섬유는 농도 증가에 따라 [TeX:] $$190.0^{\circ} \mathrm{C}$$에서 [TeX:] $$185.5^{\circ} \mathrm{C}$$로 감소하였으며, 괴각 60% 에탄올 추출물을 함유한 나노섬유의 [TeX:] $$\mathrm{T}_{\mathrm{m}}$$은 [TeX:] $$188.6^{\circ} \mathrm{C}$$에서 [TeX:] $$185.7^{\circ} \mathrm{C}$$로 감소하였다. 또한, 괴화 물 추출물을 함유한 나노섬유의 [TeX:] $$\mathrm{T}_{\mathrm{m}}$$은 [TeX:] $$191.9^{\circ} \mathrm{C}$$에서 [TeX:] $$186.6^{\circ} \mathrm{C}$$로 감소하였으며, 괴화 60% 에탄올 추출물을 함유한 나노섬유의 [TeX:] $$\mathrm{T}_{\mathrm{m}}$$은 [TeX:] $$190.6^{\circ} \mathrm{C}$$에서 [TeX:] $$186.5^{\circ} \mathrm{C}$$로 감소하였다. 융해 엔탈피[TeX:] $$\left(\Delta \mathrm{H}_{\mathrm{m}}\right)$$의 경우, 괴각 물 추출물을 함유한 나노섬유는 농도가 증가함에 따라 -36.82 J/g -32.15 J/g으로 감소하였으며, 괴각 60% 에탄올 추출물을 함유한 나노섬유의 [TeX:] $$\Delta \mathrm{H}_{\mathrm{m}}$$은 -38.38 J/g에서 -26.39 J/g으로 감소하였다. 또한, 괴화 물 추출물을 함유한 나노섬유의 [TeX:] $$\Delta \mathrm{H}_{\mathrm{m}}$$은 -42.24 J/g에서 -23.79 J/g으로 감소하였으며, 괴화 60% 에탄올 추출물을 함유한 나노섬유의 [TeX:] $$\Delta \mathrm{H}_{\mathrm{m}}$$은 -43.46 J/g에서 -35.37 J/g으로 감소하여 융해에 필요한 에너지가 감소하였다. 이는 물리적 결합과 수소결합에 의한 결정성 감소로 인해 [TeX:] $$\mathrm{T}_{\mathrm{m}} \text { 과 } \Delta \mathrm{H}_{\mathrm{m}}$$은 추출물 함량이 증가함에 따라 결정성이 저하되어 융해에 필요한 에너지가 감소했기 때문으로 추측된다[35].
3.6. 회화나무/PVA 나노섬유의 ABTS 라디칼 소거 활성
제조된 회화나무/PVA 나노섬유는 괴각 물 추출물은 첨가된 모든 농도에서, 괴각 60% 에탄올 추출물과 괴화 물 추출물에서는 5%와 10% 농도에서, 괴화 60% 에탄올 추출물에서는 5%에서 직경이 작고 균일한 섬유를 얻을 수 있었다. 고농도로 첨가할수록 전기방사성이 떨어지는 반면, 항산화 및 항균 활성이 증가하므로 가장 우수한 기능성 회화 나무/PVA 나노섬유를 제조하기에 어떤 조건이 적절한지 탐색이 필요하다. 따라서 각 부위와 용매별로 첨가 농도가 가장 큰 괴각 물 추출물 20 wt%, 괴각 60% 에탄올 추출물 10 wt%, 괴화 물 추출물 10 wt%, 괴화 60% 에탄올 추출물 5 wt%가 함유된 PVA 나노섬유를 선정하여 항산화 활성을 평가하였다. 선정된 4종류의 PVA 나노섬유의 ABTS 라디칼 소거능을 평가한 결과는 Figure 7에 나타내었다. 라디칼 소거능은 150분 경과 후 모두 100%에 근접한 결과를 보여 회화나무 추출물이 나노섬유 상태에서도 항산화 효과가 유지됨을 알 수 있다. 항산화 활성 속도는 괴각 물 추출물 20 wt%, 괴화 물 추출물 10 wt%를 함유한 나노섬유가 상대적으로 괴각 60% 에탄올 추출물 10 wt%, 괴화 60% 에탄올 추출물 5 wt%를 함유한 나노섬유보다 빠른 것으로 나타났다. 이는 ABTS 라디칼 소거 반응 시, 항산화 효과가 있는 추출물의 성분이 가진 전자가 양이온화된 라디칼([TeX:] $$ABTS^+$$)로 이동하면서 라디칼을 환원시키는 방식으로 이루어지며[36] 물의 극성이 더 높아 이온화가 더 빠르게 일어난 것으로 추측된다[37].
Figure 7.

3.7. 회화나무/PVA 나노섬유의 항균성
항균성은 항산화 활성 평가와 마찬가지로 각 부위와 용매별로 첨가 농도가 가장 큰 괴각 물 추출물 20 wt%, 괴각 60% 에탄올 추출물 10 wt%, 괴화 물 추출물 10 wt%, 괴화 60% 에탄올 추출물 5 wt%가 함유된 PVA 나노섬유를 선정하여 평가하였다. 제조된 회화나무/PVA 나노섬유의 항균성을 평가한 결과는 Table 3, Figure 8에 나타내었다. 괴각 추출물을 함유한 나노섬유는 괴화 추출물을 함유한 나노섬유에 비해 황색포도상구균에 대한 항균성은 높게 나타난 반면, 대장균에 대한 항균성은 낮게 나타났다. 괴각과 괴화는 서로 다른 약재명으로 취급되며 생물학적 성분 구성이나 전통적으로 활용된 분야에 다소 차이가 있다[38]. 괴화는 습진과 피부 발진 등 염증을 가라앉히고 치질이나 눈의 충혈, 장 내부 출혈 등의 항출혈 작용을 하며, 괴각에는 화상 및 골절 회복, 여성의 산후조리 등 다양한 효능이 보고된다[10]. 또한, 괴각에 함유된 소포리코사이드가 지질 대사, 산화 및 염증을 조절하며 접촉성 피부염 개선에도 효과적인 것으로 알려졌다[39]. 대장균은 식중독을 일으키며[40] 황색포도상구균은 상처 감염을 일으키는 대표적인 병원체로 알려져 있으며[41] 괴화에는 구강병원균에 대한 항균성이, 괴각은 그람양성균 및 그람음성균, 특히 다제내성균(multidrug-resistant pathogens)에 대해 높은 효능이 보고된다[42]. 이러한 괴긱과 괴화 추출물의 뚜렷한 항균 활성은 각 추출물의 서로 다른 식물화학적 성분 구성과 그람 양성균 및 그람 음성균의 구조적 차이와 관련이 있는 것으로 보인다. rutin과 같은 플라보노이드가 풍부한 괴화 추출물은 대장균에 대해 상대적으로 강한 항균 활성을 나타냈는데, 이는 아마도 막 투과성 저해 및 DNA 자이라제 관련 경로 억제를 통해 이루어진 것으로 추정된다. 반면, genistin과 sophoricoside과 같은 이소플라보노이드를 함유한 열매 추출물은 황색포도상구균에 대해 더 높은 효능을 보였는데, 이는 그람 양성균에 더욱 효과적인 막 표적화 및 세포벽 손상 기전 때문일 가능성이 높다. 이러한 결과는 부위별 식물화학적 성분이 항균성에 영향을 미칠 수 있음을 시사하며, 이는 항균 상처 드레싱 응용 분야에 전략적으로 활용될 수 있다.
4. 결 론
본 연구에서는 괴각과 괴화를 각각 물과 60% 에탄올을 용매로 추출하여 항산화 효과를 평가하고 전기방사를 통해 괴각과 괴화 추출물을 첨가한 PVA 나노섬유를 제조하였다. 적절한 회화나무 추출물의 농도를 찾기 위해 전기방사된 나노섬유의 형태를 확인하고, PVA 고분자와 회화나무 추출물의 적합성(compatibility)을 확인하기 위해 물리화학적 구조 변화를 분석하였으며, 제조된 회화나무/PVA 나노 섬유의 항산화 효과, 항균성을 살펴보았다.
회화나무 추출물의 총 폴리페놀 및 플라보노이드 함량을 측정한 결과, 괴각보다 괴화, 물보다 60% 에탄올 용매 추출물에서 더 높은 함량이 나타났으며 DPPH 및 ABTS 라디칼 소거능 역시 같은 경향성을 나타냈다. 추출물의 함량이 증가할수록 평균 직경과 표준편차가 증가하는 경향을 보였으며, 고농도인 20 wt%에서 괴각 물 추출물을 제외하고 비교적 크고 불균일한 직경의 섬유가 관찰되어 괴각 물 추출물은 첨가된 모든 농도에서, 괴각 60% 에탄올 추출물과 괴화 물추출물에서는 5%와 10% 농도에서, 괴화 60% 에탄올 추출물에서는 5%에서 균일한 직경의 섬유를 얻을 수 있었다. 제조된 회화나무/PVA 나노섬유의 적외선 흡수 스펙트럼과 열분석 결과, 회화나무 추출물과 PVA 고분자는 물리적 및 수소 결합을 이루었으며 적절한 농도에서 효과적으로 결합하였고, 추출물의 농도가 증가할수록 감소하여 나노섬유의 결정성이 저하되었음을 확인하였다. ABTS 라디칼 소거능은 150분 경과 후 모두 100%에 근접한 결과를 보여 회화나무 추출물이 나노섬유 상태에서도 항산화 효과가 유지됨을 확인하였으며, 항산화 활성 속도는 60% 에탄올 용매보다 물을 용매로 한 추출물이 보다 빠른 것으로 나타났다. 대장균에 대한 항균성은 괴화 추출물을 함유한 나노섬유에서 높게 나타났으나, 황색포도상구균에 대한 항균성은 괴각 추출물을 함유한 나노섬유에서 보다 높게 나타났다. 괴화와 괴각 추출물에서 관찰된 항균성은 주요 플라보노이드 및 이소플라보노이드 성분의 차이에 기인할 수 있다. 이러한 부위별 특이적 활성은 표적 항균 상처 드레싱 적용에 유용한 정보를 제공한다.
이상의 결과를 통해 회화나무의 부위 및 용매에 따른 항산화 효과 및 PVA 나노섬유 제조 특성을 확인하였다. 항산화 효과는 괴각에 비해 괴화가 높게 나타났으나, 고농도에서는 괴각이 더욱 안정적인 전기방사성을 보였다. 또한, 괴화는 대장균에 대한 항균성이, 괴각은 황색포도상구균에 대한 항균성이 더 높게 나타나 적용하고자 하는 응용 분야에 따라 활용할 수 있을 것으로 예상된다. 그러나 PVA의 매우 높은 친수성 때문에 실제 적용 및 취급이 어렵다는 한계가 있다. 또한, 가교되지 않은 회화나무/PVA 나노섬유는 ABTS 라디칼 소거능 측정 시, 용액에 즉시 녹아 시간별로 나노 섬유에서 용출되는 추출물의 항산화 효과를 확인하기는 어려웠다. 향후 연구에서는 가교 과정을 거쳐 응용 분야별 기능성을 평가하고 실제 활용 가능성을 검증하는 연구가 필요할 것으로 사료된다.
감사의 글: 이 논문은 2025-1(전기) 파안장학문화재단의 지원을 받아 수행된 연구임.
References
- 1 A. Schneider, X. Y. Wang, D. L. Kaplan, J. A. Garlick, and C. Egles, "Biofunctionalized Electrospun Silk Mats as a Topical Bioactive Dressing for Accelerated Wound Healing", Acta Biomater., 2009, 5, 2570−2578.custom:[[[-]]]
- 2 J. S. Choi, K. W. Leong, and H. S. Yoo, "In vivo Wound Healing of Diabetic Ulcers Using Electrospun Nanofibers Immobilized with Human Epidermal Growth Factor (EGF)", Biomater., 2008, 29, 587−596.custom:[[[-]]]
- 3 H. Adeli, M. T. Khorassani, and M. Parvazinia, "Wound Dressing Based on Electrospun PVA/chitosan/starch Nanofibrous Mats: Fabrication, Antibacterial and Cytocompatibility Evaluation and in vitro Healing Assay", Int. J. Biol. Macromol., 2019, 122, 238−254.custom:[[[-]]]
- 4 Y. Hao, X. Lin, W. Liu, T. Jiang, X. Zhang, S. Yang, Y. Huang, W. Lai, C. Fu, and Z. Zhang, "Development of Nanofiber Facial Mask Inspired by the Multi-function of Dried Ginger (Zingiberis Rhizoma) Essential Oil", Sci. Rep., 2025, 15, 402.custom:[[[-]]]
- 5 F. Rostami, J. Yekrang, N. Gholamshahbazi, M. Ramyar, and P. Dehghanniri, "Under-eye Patch Based on PVA-gelatin Nanocomposite Nanofiber as a Potential Skin Care Product for Fast Delivery of the Coenzyme Q10 Anti-aging Agent: in vitro and in vivo Studies", Emergent Mater., 2023, 6, 1903− 1921.custom:[[[-]]]
- 6 W. T. Su and M. S. Hsu, "Nanofiber Mask Fabrication by Electrospun and Its Application", J. Phys.: Conf. Ser., 2020, 1637, 012102.custom:[[[-]]]
- 7 O. D. Abodunrin, M. Bricha, and K. El Mabrouk, "Evaluating the Bioactive Capability and Analysis of Amoxicillin Release Mechanisms in PCL/PVP Nanofibers using Bioactive Glass as a Drug Carrier", Biomed. Mater. Devices, 2026, 4, 741−763.custom:[[[-]]]
- 8 https://species.nibr.go.kr/home/mainHome.do?cont_link=009& subMenu=009002&contCd=009002&pageMode=view&ktsn= 1200000621 (Accessed October 28, 2025).custom:[[[https://species.nibr.go.kr/home/mainHome.do?cont_link=009&subMenu=009002&contCd=009002&pageMode=view&ktsn=1200000621(AccessedOctober28,2025)]]]
- 9 C. X. Jiang, "Evaluation of Antibacterial Activity of Extracts from Sohpora japonica L. and Sanchi flower: Optimizaton using CCD-RSM", Master’s Thesis, Dankook University, Yongin, South Korea, 2023.custom:[[[-]]]
- 10 C. Kwon, J. R. Ro, Y. D. Park, H. T. Yu. (Trans. D. I. Kim), "Hyangyak Jipseongbang (The Collection of Native Korean Prescriptions)", Yegang Publishing, Seoul, 2001.custom:[[[-]]]
- 11 S. J. Park, B. H., Chung, Y. S. Choi, S. H. Park, and J. D. Kim, "Nutritional Characteristics and Bioactive Components Contents of Flos Sophora Japonica", J. Physiol. & Pathol. Korean Med., 2007, 21, 171−180.custom:[[[-]]]
- 12 S. S. Kim, S. J. Park, N. Y. Kim, and S. H. Kim, "Quantitative Analysis of Flavonoid Glycosides in Sophora japonica and Sophora flavescens by HPLC-DAD", Nat. Prod. Sci., 2021, 284− 292.custom:[[[-]]]
- 13 M. Dasha and S. Sebastian, "Antioxidant and Stabilization activity of a Quercetin-containing Flavonoid Extract Obtained from Bulgarian Sophora japnonica L.", Braz. Arch. Biol. Technol., 2013, 56, 431−438.custom:[[[-]]]
- 14 H. S. Song and H. I. Jang, "Study on the Effects of the Extracts from Sophora japonica L. Flowers, Fruits and Branches on Improvements in Skin Condition", J. Soc. Cosmet. Scientists Korea, 2016, 42, 351−358.custom:[[[-]]]
- 15 D. K. Chung and S. I. Lee, "Comparison of Parmacological Effects of Sophorae and Sophorae fructus", J. East-West Med., 1985, 10, 5−18.custom:[[[-]]]
- 16 V. T. Bartels in "Handbook of Medical Textiles" (L. Van Schueren and K. Clerck Eds.), Woodhead Publishing, Cambridge, 2011, pp.547−560.custom:[[[-]]]
- 17 M. A. Heris, A. Jahandideh, A. Akbarzadeh, and P. Mortazavi, "Dual-Loaded Poly(e-caprolactone) Nanofibers for Woundcustom:[[[-]]]